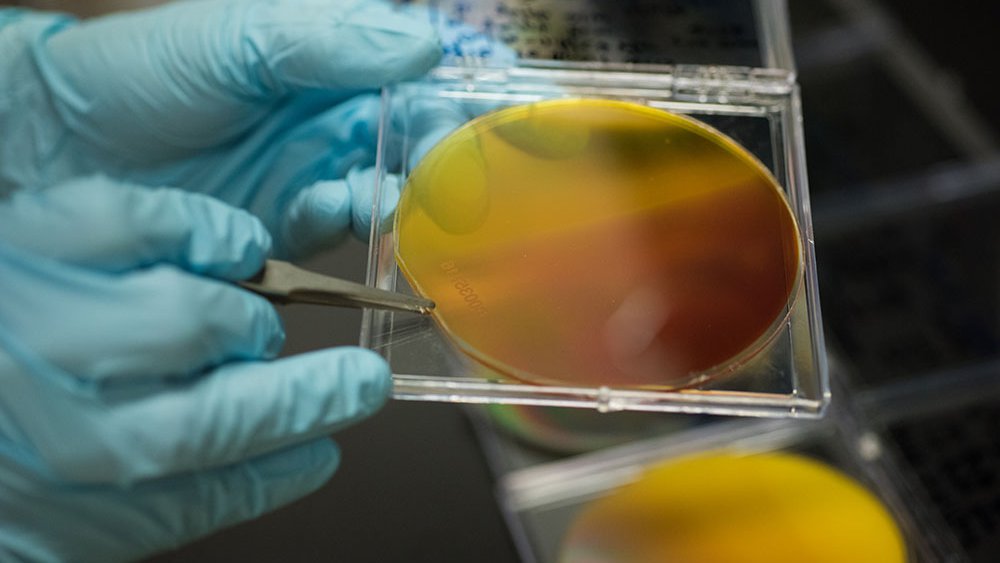
Solar fuels

Research
Caltech is small but prizes excellence and ambition. The Institute's extraordinary faculty, students, postdoctoral scholars, and staff are expanding our understanding of the universe, shifting paradigms, launching new fields, and inventing the technologies of the future. They are producing transformative breakthroughs in fields ranging from quantum science and engineering to bioinformatics and the nature of life itself, from human behavior and economics to energy and sustainability.
Caltech is home to more than 50 research centers and institutes. Some 90 percent of Caltech undergraduates participate in research during their time here.
NASA facilities on campus
Nobel Prizes
percent of students participate in research
research centers and institutes

- Graduate Student
Maegan Tucker
Maegan Tucker moves people. As a first-year graduate student in mechanical engineering at Caltech, she developed an accessory for walking canes that vibrates to alert users when they may be in danger of falling. She researches ankle exoskeletons that could help people with ambulatory impairments walk farther with less effort, and full-body suits that could return mobility to those who have lost it.

- Professor of Physics
Rana Adhikari
Most days, Caltech physics professor Rana Adhikari shoots lasers at mirrors, crystals, and film-coated glasses to see how photons of light interact with them. What he learns helps him design optical systems and sensors for LIGO, the Laser Interferometer Gravitational-wave Observatory, and its successors.

- Professor of Biology
Lea Goentoro
Caltech professor of biology Lea Goentoro and her students will try to persuade the moon jellyfish, an organism not known to regenerate in the wild, to regrow appendages.

- Bren Professor of Chemistry
Garnet Chan
Garnet Chan appreciates a good challenge. A Caltech theorist who works at the interface of theoretical chemistry, condensed matter physics, and quantum information theory, Chan says he is drawn to scientific problems that have long resisted theoretical study.